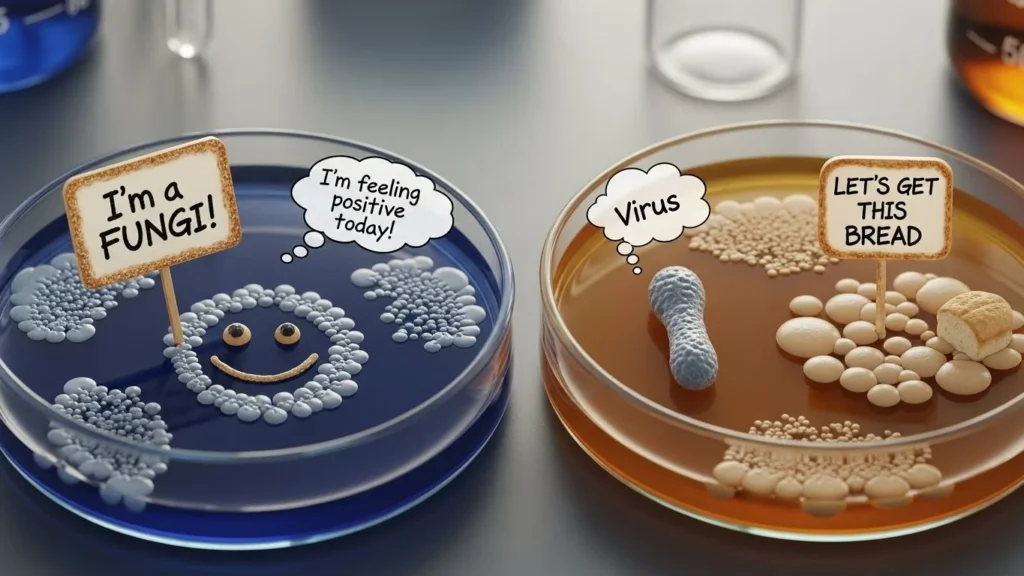
microbiology puns

Ready to zoom into some tiny-but-mighty humor? Microbiology puns mix science smarts with playful wordplay, creating jokes that are both clever and laugh-out-loud funny. From cells to cultures, these puns prove that even the smallest things can bring the biggest smiles.
Whether you’re a student, a science lover, or just here for some brainy laughs, this collection of microbiology puns is sure to grow on you. Get ready to giggle, grin, and enjoy some truly culture-rich humor!

🦠 Microbiology Puns One Liners
I’m into small talk—very small
That joke was contagious
Stay positive, like a culture
I’m feeling cell-f confident
Bacteria late than never
This lab has good vibes
I’ve got a growing interest
That idea has potential
I’m cultured, literally
Don’t be so negative
🔬 Short Microbiology Puns
Cell yeah
Germ-azing
Tiny but mighty
Culture club
Lab life
Pure culture
Mic drop
Spore-tacular
Petri perfect
Good growth

💬 Microbiology Puns Reddit
My personality is lab-grown
I trust people who label their samples
My humor is microscopic
I’m emotionally cultured
My jokes are highly contagious
This thread has good growth
I’m here for the lab memes
Petri dish is my comfort zone
I don’t ghost—I incubate
Science but make it funny
📸 Microbiology Puns Captions
Living that lab life
Too cool for culture
Microscopic mood
Stay cultured
Good vibes only
Small things matter
Nerd but make it cute
Powered by coffee and curiosity
Growing daily
In my science era
😏 Microbiology Puns Dirty (Playful Only)
You make my cells react
Our chemistry is real
I’m feeling highly cultured
You make my nucleus spin
That spark was electric
Let’s keep it scientific
I’m attracted at a molecular level
This vibe is infectious
We’ve got good chemistry
My heart is replicating
🧬 Amoeba Puns
Amoeba-lieve in yourself
Amoeba-lous day
Just splitting my time
I’m feeling extra single-celled
Amoeba besties
No nucleus, no stress
Amoeba-zing vibes
Simple life, big dreams
Dividing my worries away
Amoeba my Valentine
🤒 Disease Jokes (Light & Non-Offensive)
I’m sick… of bad jokes
That pun was viral
My humor is spreading
I caught feelings, not germs
This joke is contagious
That laugh was infectious
I’ve got a fever… for science
My mood is going around
Don’t worry, it’s pun-only
Totally harmless humor
🧩 Microbiology Riddles With Answers
What do you call a bacteria that tells jokes?
Answer: A fun-guyWhy did the bacteria cross the microscope?
Answer: To get a closer lookWhat’s a microbe’s favorite music?
Answer: Heavy metalWhy was the cell so calm?
Answer: It had inner peaceWhy did the amoeba break up?
Answer: Too many splitsWhat do microbes read?
Answer: Germ-nalsWhy did the scientist bring a ladder?
Answer: To reach higher cultureWhat’s a germ’s favorite sport?
Answer: Culture wrestlingWhy was the bacteria so confident?
Answer: It had good growthWhat did the microbe say to the petri dish?
Answer: I’m growing on you
🦠 Microbiology Puns One-Liners
I’m so over bacteria… they’re just germ-inal problems.
Never date a fungus — they’re too spore-tive.
Microbiologists never party alone — they always bring cultures.
Viruses are so rude… they just invade without asking.
I’m friends with bacteria — they really grow on you.
My lab partner is so bright… she’s a real culture shock.
I told a germ joke… it got a viral reaction.
Fungi make terrible roommates — they’re always mold-y.
Microbiologists don’t need dating apps — they just culture connections.
I don’t trust bacteria… they’re always splitting up.
🧫 Short Microbiology Puns
Germ me up!
Stay culture-d.
Don’t be mold.
Spore you later.
Totally viral.
Amoeba-ing silly.
Cell-fie time.
Bacteria besties.
Lab life = petri-fied.
Just a micro win.
🧬 Mutation Puns
Mutating into laughter.
Randomly funny.
A mutation of puns.
Natural selection for humor.
Adapt or giggle.
Evolving jokes nonstop.
Fitness is funny-ness.
Mutation station of comedy.
Survival of the punniest.
Variations on laughter.
🦠 Antibiotic Resistance Puns
These jokes can’t be killed.
Resistance is pun-tile.
Multidrug humor.
No cure for laughter.
The jokes just keep growing.
MRSA lot of laughs.
Penicillin’t stop me.
Breakthrough comedy.
Dose of giggles daily.
Unstoppable humor strain.
🧪 Microscopy Puns
Zoom into laughter.
Focus on the fun.
Slide into the joke.
Magnify your smile.
Lens me your ears.
Scanning electron fun.
Light up your day.
Scope out some humor.
Immersion oil of joy.
Tiny world, big laughs.
🥛 Fermentation Puns
I’ve got a bubbly personality.
Let’s brew some fun.
Cheers to microbes.
Culture on tap.
Hoppy to be here.
Wine not laugh?
Distilled joy.
Spirits lifted daily.
Kombucha know it’s funny?
Fermenting smiles everywhere.
🧫 Cell Structure Puns
Membrane your manners.
Don’t let it cell you short.
Nucleus of the party.
Cytoplasm-tastic.
Wall of laughter.
Ribosome jokes nonstop.
ER you ready to laugh?
Golgi all the way.
Mito-chondrially funny.
Vacuole up the humor.
🦠 Epidemiology Puns
Outbreak of laughter.
Spread the joy, not the germs.
Patient zero of comedy.
Infecting smiles worldwide.
Curve-flattening humor.
Case study in giggles.
Pandemic of puns.
Transmission complete.
Pathways to fun.
Endemic chuckles.
🧬 Evolutionary Microbiology Puns
Microbes were the OGs.
Origin of giggles.
Darwin would be proud.
Natural pun selection.
Fossil fuel for laughter.
Survival of the chuckliest.
Adapt and laugh.
Evolution is a joke itself.
Branching out in humor.
Small changes, big laughs.
🧪 Biotech & Microbiology Puns
Gene-splicing some fun.
Clone and groan.
PCR your way to laughter.
Amplify the giggles.
Cutting-edge humor.
Recombinant fun.
Plasmid of joy.
Vector of comedy.
Sequencing smiles daily.
Modified for laughter.
🦠 Parasitology Puns
I’m hooked on you.
Don’t leech my happiness.
Worming my way into jokes.
Malaria? More like Malaughria.
Tickled by humor.
Host with the most.
Living rent-free.
Infestation of laughter.
Outbreak of smiles.
I’m flea-ing with joy.
🧫 Petri Dish Puns
I’ve got some culture to share.
Let’s dish out the laughs.
That joke really grew on me.
Petri-fied with laughter.
Spreading positivity one colony at a time.
It’s agar-ious humor.
Growing jokes overnight.
Dish it and wish it.
I’m in my growth phase.
You’ve cultured my heart.
🦠 Bacteria Puns
Don’t bac-down from a joke.
Stay positive, not Gram-negative.
Good vibes only—no pathogens.
Bacteria always find the right culture.
Stop acting so bac-terious.
Germ-inating laughter daily.
Divide and conquer the humor.
I’m feeling culture shock.
Resistance is futile, like antibiotics.
Germs but make it funny.
🧬 DNA & Genetics Puns
You’ve got the gene for comedy.
It’s in my DNA to laugh.
Double helix, double the fun.
Mutations keep life interesting.
You’re one of a kind allele.
I’m helically twisted with joy.
My genes express happiness.
A little pun never hurt my genome.
Inherit the humor.
Coding for laughter.
🧫 Lab Equipment Puns
I’m centrifugally spun out.
Beaker of joy.
Microscope your worries away.
I’ve got test-tube humor.
Flask-tastic jokes.
Don’t pipette me down.
Incubator of fun.
Keep it sterile but silly.
Slide into my jokes.
Petri-perfect punchlines.
🍄 Fungi Puns
I’m a real fun-gi.
Don’t spore-get to laugh.
Shroom for humor.
Mycelium makes me smile.
Fungi always know how to party.
Spores and giggles.
Yeast of all worries.
Fungalicious laughter.
Mushroom with a view.
Lichen these puns a lot.
🦠 Virus Puns
Viral humor spreads fast.
Don’t flu away from a laugh.
Stay positive, not viral.
Catching laughs, not colds.
Influenza of fun.
Corona of comedy.
Mutate into giggles.
Infectious humor alert!
RNA real funny joke.
Laughing is contagious.
🧪 Chemistry Meets Microbiology Puns
We’ve got good bonding.
Atom-ic laughs.
Don’t react negatively.
My solution is puns.
Periodically funny.
Lab-partners forever.
Keep calm and titrate on.
Proton your humor.
Neutrons have no charge, just like this joke.
Chemical romance with microbes.
🌱 Environmental Microbiology Puns
Eco-friendly and micro-funny.
Compost your worries.
Recycling laughs daily.
Microbes make the world go round.
Soil mates forever.
Breathe easy, microbes got this.
Clean air, dirty jokes.
Sewage never sounded so funny.
Nature’s little recyclers.
Groundbreaking humor.
🍞 Food Microbiology Puns
This joke is well-cultured.
Rise to the occasion like yeast.
Breadwinner of humor.
Fermenting fun every day.
Pickled with laughter.
Dairy funny, isn’t it?
Gouda-bye germs.
Beer-y good jokes.
Kombucha keep laughing.
Say cheese!
🏥 Medical Microbiology Puns
Diagnosis: pun addiction.
Antibiotics won’t cure my humor.
Infected with laughter.
Clinic-ally funny.
Doc says I need more jokes.
Germ ward is full of puns.
Vaccinated against boredom.
Hospital-ity with humor.
Treatment plan: giggles.
Cure is laughter.
🔬 Random Silly Microbiology Puns
Don’t stress, just express.
A little lab love goes a long way.
Laughing under the microscope.
Cultures of joy.
It’s a small world after all.
Lab life, pun life.
Don’t stain your day with worry.
Good puns never die, they just divide.
Small but mighty jokes.
Laughter is universal—like microbes.
FAQs?
Q: Why are microbiology puns so popular?
A: Because they’re small but spread fast—just like microbes!
Q: Can microbiology puns be used as Instagram captions?
A: Absolutely, they’re culture-approved and witty for any science selfie.
Q: Are these puns lab-safe?
A: 100% sterile humor guaranteed.
Q: What’s a biologist’s favorite type of humor?
A: Inside jokes.
Q: How do microbes flirt?
A: They say, “You’ve got me under the microscope of love.”
Q: Why did the bacterium fail its test?
A: It couldn’t handle the pressure in the lab.
Q: Are fungi funny?
A: Of course—they’re fun-guys!
Q: Can microbiology jokes go viral?
A: Yes, and they usually mutate into new ones.
Q: What do microbes do at parties?
A: They culture the vibe.
Q: Is laughter really contagious?
A: Definitely—it’s the best kind of infection.
Conclusion
And there you have it— microbiology puns that prove even the tiniest organisms can generate the biggest laughs. Whether you’re cracking jokes in the lab, writing captions, or just sharing nerdy humor with friends, these puns are guaranteed to multiply smiles faster than bacteria in a petri dish.
If you loved these, you’ll find even more pun-filled treasures over at punsnetwork.com—because good humor is always worth cultivating!